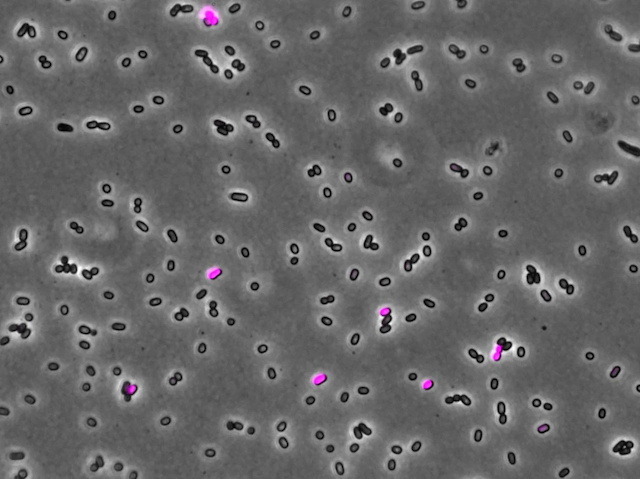

Insight into how mobile pieces of DNA control the bacterial cells they jump between
28 October 2020
Pass it On
Inside these unassuming bacteria lurks a rogue element known only by the codename ICEclc. It’s an example of a mobile genetic element – a small piece of DNA that can jump from one bacterial cell to another, often carrying useful information such as genes for antibiotic resistance. ICEclc usually lurks quietly within the DNA of its host but sometimes it can take over, hijacking the host cell and making more copies of itself that can be passed on (hijacked cells are highlighted in pink in this image). Although it’s helpful for bacteria to harbour ICEclc and benefit from its antibiotic resistance genes, the process of copying and passing it on actually prevents bacteria from multiplying themselves. Figuring out how ICEclc and its hosts maintain their truce and what happens when it breaks down could lead to new strategies for combating the spread of antibiotic resistance – a major global health problem.
Written by
Search The Archive
Submit An Image
Like us on Facebook
Follow on Twitter
Follow on Tumblr
Follow on Instagram
What is BPoD?
BPoD stands for Biomedical Picture of the Day. Managed by the MRC Laboratory of Medical Sciences until Jul 2023, it is now run independently by a dedicated team of scientists and writers. The website aims to engage everyone, young and old, in the wonders of biology, and its influence on medicine. The ever-growing archive of more than 4000 research images documents over a decade of progress. Explore the collection and see what you discover. Images are kindly provided for inclusion on this website through the generosity of scientists across the globe.
BPoD is also available in Catalan at www.bpod.cat with translations by the University of Valencia.








